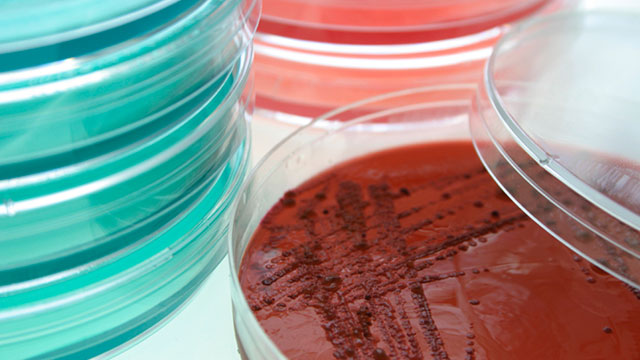

水套式
二氧化碳培養箱的溫度是通過電熱絲給水套內的水加熱 , 再通過箱內溫度傳感器來檢測溫度變化, 使箱內的溫度恒定在設置溫度。氣套式
二氧化碳培養箱的加熱是通過遍布箱體氣套層內的加熱器直接對內箱體進行加熱的 , 又叫六面直接加熱。氣套式與水套式相比 , 具有加熱快 , 溫度的恢復比
水套式培養箱迅速的特點 , 特別有利于短期培養以及需要箱門頻繁開關的培養。箱內溫度一般設定在 37 ℃±0.2 ℃左右。
CO2培養箱控制二氧化碳的濃度是通過二氧化碳濃度傳感器來進行的。二氧化碳傳感器用來檢測箱體內二氧化碳濃度 , 將檢測結果傳遞給控制電路及電磁閥等控制器件 , 如果檢測到箱內二氧化碳濃度偏低 , 則電磁閥打開 , 二氧化碳進入箱體內 , 直到二氧化碳濃度達到所設置濃度, 此時電磁閥關閉 , 箱內二氧化碳切斷 , 達到穩定狀態。二氧化碳采樣器將箱內二氧化碳和空氣混合后的氣體取樣到機器外部面板的采樣口 , 以隨時用二氧化碳濃度測定儀來檢測二氧化碳的濃度是否達到要求。
目前大多數的
CO2培養箱是通過增濕盤的蒸發作用產生濕氣的 (其產生的相對濕度水平可達 95 %左右, 但開門后濕度恢復速度很慢)。因為濕度蒸發面積越大, 越容易達到**大相對飽和濕度并且開關門后的濕度恢復的時間越短。所以濕度蒸發面積大的
培養箱較濕度蒸發面積小的
培養箱容易保持**大相對飽和濕度。